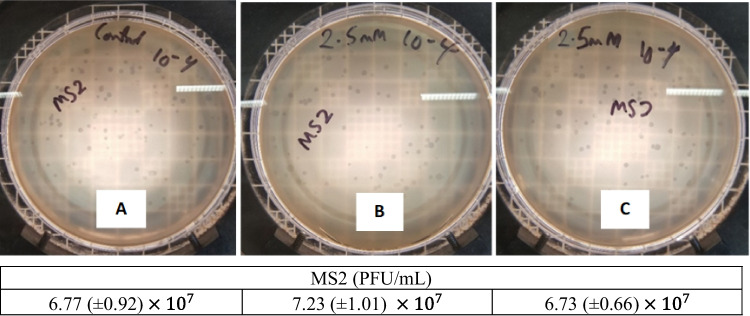
Fig. 9

Abstract
The COVID-19 pandemic involving SARS-CoV-2 has raised interest in using antimicrobial lipid formulations to inhibit viral entry into their host cells or to inactivate them. Lipids are a part of the innate defense mechanism against pathogens. Here, we evaluated the use of nano-monocaprin (NMC) in inhibiting enveloped (phi6) and unenveloped (MS2) bacteriophages. NMC was prepared using the sonochemistry technique. Size and morphology analysis revealed the formation of ~ 8.4 ± 0.2-nm NMC as measured by dynamic light scattering. We compared the antiviral activity of NMC with molecular monocaprin (MMC) at 0.5 mM and 2 mM concentrations against phi6, which we used as a surrogate for SARS-CoV-2. The synthesized NMC exhibited 50% higher antiviral activity against phi6 than MMC at pH 7 using plaque assay. NMC inactivated phi6 stronger at pH 4 than at pH 7. To determine if NMC is toxic to mammalian cells, we used MTS assay to assess its IC50 for HPDE and HeLa cell lines, which were ~ 203 and 221 µM, respectively. NMC may be used for prophylactic application either as a drop or spray since many viruses enter the human body through the mucosal lining of the nose, eyes, and lungs.
Keywords: Antimicrobial lipids, Coronavirus surrogate, Bacteriophage, Molecular monocaprin, Nano-monocaprin
Introduction
Global outbreaks of severe acute respiratory syndrome coronavirus 2 (SARS-CoV-2) have raised significant concerns regarding the persistence, transmission, and inactivation of enveloped viruses. Multiple approaches have been tried to inactivate or prevent the entry of SARS-CoV-2 into the host cells (Wanda et al. 1976, Sands 1977, Kohn et al. 1980, Tseng and Li 2007, Qiao et al. 2020, Wood et al. 2020, Vatter et al. 2021). These methods used other coronaviruses or phi6 as surrogate for enveloped viruses such as SARS-CoV-2 (Table 1). However, some of these demonstrated approaches may have damaging consequences on human cells and sensitive material surfaces. Therefore, their practical applications directly to humans are limited. This concern has led to renewed interest in antimicrobial lipids as a natural line of defense against invading pathogens such as SARS-CoV-2 (Fletcher et al. 2020).
Table 1.
Techniques, concentration, contact time, and log reduction of several viral decontamination studies
| Techniques | Concentration | Contact time | Log reduction level |
References |
|---|---|---|---|---|
| Photoinactivation by visible violet light |
1300 J cm−2 of 405 nm irradiation for phi6 |
1.5, 3, 4.5 h | 3 | (Vatter et al. 2021) |
| Ultraviolet germicidal |
2.51–6.50 mJ cm−2 for MS2 7.75–10.57 mJ cm−2 for phi6 |
5–255 s | 2 | (Tseng and Li 2007) |
| Hydrogen peroxide vapor (HPV) | > 400 ppm for phi6 | 24–32 h | 2–6 | (Wood et al. 2020) |
|
Ducted ultraviolet-C (UV-C) system |
13.9–49.6 mJ cm−2 at 253 ± 1 nm for respiratory coronavirus (ATCC VR-2384) | 1.3–5.1 s | > 3 | (Qiao et al. 2020) |
| Butylated hydroxytoluene (BHT) and hydroxyanisole (BHA) | 3 × 10−5 M for phi6 | 30–75 min | 2 | (Wanda et al. 1976) |
|
Fatty acids (oleic and palmitoleic acid) |
50 µg/mL | 30 min | 2 | (Sands 1977) |
|
Nano monocaprin (NMC) |
1–2 mM for phi6 | 1–5 min | 7 | This study |
Antimicrobial lipids, composed of free fatty acids and monoglycerides, have been known to inhibit enveloped viruses, Gram-positive and Gram-negative bacteria for over a century (Kohn et al. 1980, Thormar 2011, Thormar et al. 2013). The antiviral and antibacterial activities of lipids have been studied extensively (Kabara et al. 1972, Kabara et al. 1977, Kabara 1978, Kristmundsdóttir et al. 1999, Thormar et al. 1999, Bergsson et al. 2001, Bergsson et al. 2002, Thorgeirsdottir et al. 2003, Thormar et al. 2006, Fletcher et al. 2020). Monoglyceride formulations have high antiviral properties relative to free fatty acids (Thorgeirsdottir et al. 2003). Monocaprin, the 1-monoglyceride of capric acid, has been recorded to rapidly inhibit the replication of enveloped viruses (Thormar et al. 1999, 2006, 2013; Thorgeirsdottir et al. 2003).
Monocaprin has a structure similar to the lipids of the natural immune system in humans (Thorgeirsdottir et al. 2003; Thormar et al. 2013). Moreover, these molecules are cheap, naturally abundant, non-toxic, and biocompatible (Kabara, 1978, Jackman et al. 2016, Churchward et al. 2018, Churchward et al. 2020). However, monocaprin has very low water solubility, limiting its use in pharmaceutical formulations. Attempts to improve the solubility of monocaprin in pharmaceutical formulations involve using co-solvent (Thorgeirsdottir et al. 2003), surfactants (Thorgeirsdottir et al. 2003; Thormar et al. 2006), and excipient (Kristmundsdóttir et al. 1999; Thormar et al. 1999). The addition of one or more inactive reagents (e.g., surfactant and co-solvent) to improve the solubility of monocaprin can affect its antiviral activity (Kristmundsdóttir et al. 1999; Thorgeirsdottir et al. 2003).
In recent years, nanotechnology has been exploited to improve antimicrobial agents' biological and chemical activities (São Pedro et al. 2013; Fernandes et al. 2014, 2016; Yariv et al. 2015; Gupta et al. 2019; Mamun et al. 2021; Tan et al. 2021). Materials at the nanoscale display higher chemical reactivities than their bulk or molecular counterpart due to the large surface area-to-volume ratio of materials in sizes between 1 to 100 nm (Xu et al. 2012; Singh et al. 2014; Yariv et al. 2015). Hence, lower minimum inhibitory concentrations (MICs) have been reported for antimicrobial agents at the nanoscale relative to bulk compounds (Yariv et al. 2015). Additionally, organic compound-based nanoparticles penetrate cells more efficiently than the bulk form. Sonochemistry, one of the earliest methods of nanomaterial fabrication, is a simple technique for generating organic nanoparticles (Suslick and Crum, 1997, Gedanken 2003, Gedanken 2004, Qiao et al. 2011). The sonochemistry technique involves an acoustic cavitation process that occurs from the application of ultrasound radiation (20 kHz–10 MHz) to a molecule causing chemical bonds to break (Gedanken 2003, Qiao et al. 2011). This technique has been used to improve the pharmacological activity of other organic compounds such as penicillin and vitamin B12 (Fernandes et al. 2014, 2016; Yariv et al. 2015).
Herein, we hypothesize that nano-monocaprin (NMC) fabricated/synthesized using simple sonochemistry techniques and without any co-solvent or surfactant will improve monocaprin solubility, producing micelles that can decorate the surface of the virus. Such structures will exhibit antiviral property by affecting the binding of the virus to the host cell. We prepared NMC through sonochemistry techniques and characterized it using dynamic light scattering (DLS) and UV–Vis spectroscopy. Thereafter, we compared the antiviral activity of NMC with MMC suspension using enveloped virus phi6 as a surrogate for SARS-CoV-2. The influence of the pH on the antiviral activity of NMC and its cytotoxicity was also examined. The inhibitory effects of NMC on coronaviruses have not yet been specifically investigated. These NMC formulations would be of particular interest with regard to the COVID-19 pandemic as they can be readily applied as surface disinfectants, skin cleaners, nasal sprays, and for other therapeutic applications in or on humans.
Materials and method
Biological and chemical reagent
Agar (VWR Life Science), tryptic soy broth (TSB) (Sigma Aldrich), ampicillin, streptomycin, monocaprin ( 98% GC grade, TCI America, Inc), Dulbecco’s modified Eagle’s medium (DMEM) (Thermo Fisher Scientific), Roswell Park Memorial Institute (RPMI) media (Corning), Fetal Bovine Serum (FBS) (Corning), penicillin–streptomycin (pen-strep) (Corning), Glutamax (Gibco), non-essential amino acids (NEAA), 1X Dulbecco’s phosphate buffer saline (DPBS) (Corning), phosphate buffered saline solution (10 mM, Sigma Aldrich), buffer solutions pH 7 and 4 (Sigma Aldrich).
Preparation and characterization of MMC and NMC
MMC was prepared in a 20-mL borosilicate glass vial by manually mixing monocaprin ( in ultrapure particle-free deionized water to obtain a stock solution of 4 mM (Fig. 1). NMC was prepared using a part of the MMC stock solution by sonochemistry technique (Yariv et al. 2015). Briefly, sonication was done using an ultrasonic cleaner (47 ± 3 kHz, Branson 2210R-MTH). NMC were prepared using two sonication patterns: intermittently (30-s sonication, 30-s manual mixing to a total of 7 min) and continuously for 20 min. During sonication, the glass container was kept sealed to prevent particle loss. Sonication produces heat because continuous cavitation creates energy and can increase water temperature (Gude and Grant 2013; Yariv et al. 2015). The maximum temperature reached over the sonication time was 30 ± 2 °C, which was below the monomers’ main-phase transition temperatures. NMC at pH 4 and pH 7 was prepared in pH buffered solutions instead of ultrapure particle-free deionized water. The absorbance spectra of MMC and NMC were determined using a Hach DR 6000™ UV–Vis Spectrophotometer. The hydrodynamic size, zeta potential, mobility, and conductivity of NMC were measured by a Malvern Zetasizer Nano- ZS spectrometer.
Fig. 1.
Schematic of NMC synthesis and antiviral assay. A MMC denotes molecular monocaprin emulsion prepared by the suspension of reagent-grade monocaprin powder in particle-free deionized water. Nano-monocaprin particles, NMC and NMC_intermittent, were synthesized by sonication of MMC. NMC was prepared by continuous sonication for 20 min, and NMC_intermittent was prepared by intermittent sonication (30-s sonication, 30-s manual mixing) for 7 min, respectively. B Phi6 and MS2 were used as surrogate virus particles to test the antiviral activity of NMC and MMC. C Cytotoxicity of NMC was examined by MTS assay against HeLa and HPDE mammalian cells
Selection of potential surrogate
After determining the scope of our experiments, i.e., disinfection of viruses with medium-chain monoglyceride, we considered both microbiological and practical aspects of selecting potential surrogates. We used Sinclair et al.'s (2012) conceptual decision framework to identify potential surrogates for pathogenic viruses based on safety, functional morphology, and expected resistance to monocaprin. To mimic pathogenic enveloped viruses, we selected a double-stranded RNA (dsRNA) enveloped phi6 bacteriophage that is non-pathogenic to humans but structurally similar to SARS-CoV-2. Phi-6 bacteriophage is a well-studied and safe surrogate for pathogenic enveloped viruses such as SARS-CoV-2, influenza virus, or Ebola virus (Ye et al. 2016; Aquino de Carvalho et al. 2017; Fedorenko et al. 2020). Phi6 is a biosafety level 1 (BSL-1) plant pathogen and practically culturable in laboratory conditions without posing any human health risk. The role of the lipid-based viral envelope is to provide resistance to disinfection and protect the viral membrane. Monocaprin has inactivation potential for lipid-containing viruses by removing or extracting the lipid-based membrane components (Thormar et al. 2013). To test this specific antiviral activity of NMC, we chose a non-enveloped MS2 bacteriophage. MS2 has a single-stranded RNA (ssRNA), similar to the genome type of SARS-CoV-2. MS2 is a surrogate of human enteric viruses (Wigginton et al. 2012).
Propagation of bacteriophage stock suspension
Phi6 (HER 102) and host bacteria Pseudomonas syringae (HER 1102) were purchased from Félix d’Hérelle Reference Center for Bacterial Viruses Université Laval (Québec, Canada). MS2 (ATCC 15,597-B1) and host bacteria E. coli HS(pFamp)R (ATCC 700,891) were purchased from the American Type Culture Collection (ATCC, USA). Stock suspensions of phi6 and MS2 were prepared using the top agar overlay technique (Wood et al. 2020). Bacteriophage was propagated using 100 µL of lyophilized bacteriophage stock mixed with 100 µL of overnight host bacteria in 5 mL of molten (55 °C) soft tryptic soy agar (TSA) (0.6% agar). The mixture was uniformly spread over hard TSA (1.5%) plates and allowed to solidify. Subsequently, agar plates were incubated for 18 h. P. syringae was incubated at , while E. coli HS(pFamp)R (ATCC 700,891) was cultured at 37 on TSA supplemented with 15 µg/mL of ampicillin and streptomycin and 2.25 mM CaCl2. Top agar with lysed bacteria cells was aseptically harvested, 15 mL of TSB added, and centrifuged at 5000 × g for 15 min. The supernatant was removed and filtered through a sterile 0.2 µm syringe filter to remove residual bacteria. Stock bacteriophage was stored at 4 for subsequent use.
Bacteriophage inactivation using NMC and MMC
Phi6 and MS2 suspensions were used at a concentration of ~ PFU/mL in TSB. The titer of the bacteriophage was determined by using the double agar overlay plaque assay. Bacteriophage inactivation experiments were carried out by mixing 500 µL of bacteriophage suspensions and 500 µL of each sample (i.e., NMC or MMC) under varying contact times (1 to 5 min). After predetermined time points, 100 µL of bacteriophage and 100 µL of CFU/mL of overnight host bacteria were mixed in 5 mL of molten soft tryptic soy agar (TSA) (0.6% agar). The mixture was uniformly spread over hard TSA (1.5%) plates and allowed to solidify. Agar plates were incubated for 18 h at conditions described in Sect. 2.4. Bacteriophages were treated with pH buffer solution and/or TSB (500 µL) as the negative control. Bacteriophage inactivation is obtained based on Eq. 1:
| 1 |
where is the concentration (PFU/mL) of bacteriophage without the addition of NMC/MMC and is the bacteriophage concentration after the addition of NMC/MMC for time .
Cytotoxicity of NMC
The CellTiter 96® AQueous One Solution Cell Proliferation Assay (MTS) was carried out to evaluate the biocompatibility of the synthesized NMC. Human Pancreatic Duct Epithelial Cells (HPDE) and HeLa cervical cancer cell lines were used for the cell viability assay to represent the effect of NMC on normal and cancer cell lines, respectively. HPDE was cultured in DMEM supplemented with 10% FBS, 1% penicillin/streptomycin, 1% Glutamax, and 1% non-essential amino acids. HeLa cells were cultured in RPMI media supplemented with 10% FBS and 1% penicillin/streptomycin. Cells were seeded in 96 well plates (1000 cells per well) and incubated overnight (5% CO2, 37 °C). Thereafter, cells were incubated with media containing ten-fold serially diluted NMC (0 to 2 mM) for 24 h (5% CO2, 37 °C). Cell viability (%) is calculated using Eq. 2:
| 2 |
where , and are the absorbance values of NMC—treated cells, untreated cells, and media respectively. IC50 values were determined by nonlinear regression of normalized cell viability data using GraphPad Prism (v8.3.0 for Windows).
Results and discussion
Characterization of NMC
The size of NPs generated by sonochemistry is influenced by the sonication time (Yariv et al. 2015). This study evaluated the influence of sonication time by testing two sonication patterns: intermittent sonication (every 30 s for 7 min) and continuous sonication for 20 min. The stock solution (4 mM) of NMC (continuous) (hereafter called NMC) appeared as a clear solution compared to the milky suspension of NMC (intermittent) (hereafter called NMC_intermittent) and MMC (Fig. 2). This result suggests an improved dispersion via continuous sonication. The size of the synthesized NMC was measured by DLS. Figure 3 shows the hydrodynamic size of NMC micelle for a 24-h period. The average hydrodynamic size of NMC was 8.4 ± 0.2 nm, which is close to a 1 mM Tween 20 micelle size of 7.2 nm (Basheva et al. 2007). The hydrodynamic size is always larger than the actual diameter of NMC micelle due to the electrical double layer surrounding micellar particles. On average, we found a 14–17% particle count (here denoted as DLS intensity in Fig. 3) in the sample for a 1-day period. The particle size did not change over time as the particle counts (intensity %) remained within a range of 14–17% for 24 h, suggesting that particles did not settle significantly. The extremely small size of the particles renders them dispersed in aqueous phase for a long time. Figure 4 shows the zeta potential, mobility, and conductivity of NMC micelles. The zeta potential, mobility, and conductivity of NMC micelles were observed to be in the range of − 15 to – 35 mV, − 1 to − 2.76 µm-cm/Vs, and 0.011 to 0.026 mS/cm, respectively. Over a period of 60 min, the mean zeta potential, mobility, and conductivity were − 22.9 mV, − 1.80 µm-cm/Vs, and 0.013 mS/cm respectively. Our results show that the synthesized anionic NMC micelles, with a mean zeta potential of − 23 mV, are near the optimal level considered as a good stabilization of a nano-dispersion (Samimi et al. 2019). Thus, NMC can sufficiently remain dispersed to interact with phi6. The absorption spectra of NMC and MMC were observed to verify that the chemical structure of monocaprin was unaltered. Figure 5 shows that MMC and NMC had similar absorption spectra. This result indicates that no structural changes occurred due to sonication. NMC had a lower absorption value than MMC because it is a clear solution compared to MMC.
Fig. 2.
Physical appearance of A MMC, B NMC_intermittent, and C NMC at 4 mM
Fig. 3.

Hydrodynamic size (in nm) of NMC particles by DLS technique
Fig. 4.

Zeta potential (mV), mobility (µmcm/Vs), and conductivity (mS/cm) of NMC
Fig. 5.

Absorbance spectra of MMC and NMC (4 mM, in nano pure water)
Antiviral effects of NMC and MMC
A longer sonication time means smaller particle size resulting in greater penetration and interaction with the lipid envelope of the virus (Thormar et al. 2013, São Pedro et al. 2013, Yariv et al. 2015). Thus, we varied the sonication time to examine if indeed NMC inhibits the viral surrogates better when sonicated longer. Figure 6 shows that at 2 mM (pH 7), NMC prepared by continuous sonication (20 min) achieved 2.5-fold higher phi6 inactivation that when prepared by intermittent sonication (7 min) after 1 min contact time. This result shows that continuous and longer sonication time achieved better antiviral activity than intermittent sonication at a very short contact time. However, after contact for 5 min, we observed no difference in the antiviral activity of NMCs sonicated for 7 and 20 min. This result suggests the time-dependent antiviral action of monocaprin. This time-dependent antiviral activity of antimicrobial lipids is reported in literature (Sands 1977, Wang and Johnson 1992; Bergsson et al. 1998). With this observation, subsequent antiviral tests were carried out using NMC prepared by continuous sonication. We observed > 7-log phi6 inactivation at 2 mM and 5 min contact time using NMC, whereas MMC resulted in only ~ 4 log inactivation (Fig. 7). This result suggests that NMC has higher reactivities than MMC due to the high surface area-to-volume ratio (Fernandes et al. 2014; Singh et al. 2014), considering the same mass in the formulations. Also, our result suggests that NMC interacted better with the lipid envelope of phi6 than MMC due to the lower propagation of NMC treated phi6 samples. This result suggests faster lysis of the lipid envelope (Thormar et al. 2013, Sands 1977, Isaacs et al. 1986).
Fig. 6.

Optimization of NMC: preparation method (2 mM, pH 7). Error bars are the standard deviation of triplicate plaque counts for each experiment condition
Fig. 7.

Inactivation of phi6 using MMC and NMC solutions at pH 7 with an exposure time of 5 min. Asterisk (*) indicates the limit of quantification. Error bars are the standard deviation of triplicate plaque counts for each experiment condition
The pH is known to influence the antimicrobial activity of monocaprin (Petschow et al. 1996; Thormar et al. 2006, 2013). To test whether the solution pH affected the activity of NMC, we compared the antiviral activity of NMC at pH 4 and 7 to enhance the MIC. At a high concentration of 2 mM NMC and 5 min contact time, we observed no difference in the antiviral activity at pH 4 and 7 (Fig. 8). However, when we used lower NMC concentrations of 0.25 and 0.5 mM, we observed a higher inhibition of the viral surrogates at acidic pH than at neutral pH. The control experiment indicates that pH 4 buffer and nano pure water achieved 0.21 (± 0.02) log inactivation of phi6. We posit that the high acidity weakens the outer lipid coat of phi6 and allows NMC to penetrate the cell (Thormar et al. 2013). This result implies that the inhibitory concentration of NMC against phi6 can be reduced using formulations at acidic pH. The effectiveness of NMC at acidic pH opens the possibility for its use in many pharmaceutical formulations. In addition to its potential use for the treatment of established infections, NMC formulations can be manufactured as a topical antimicrobial to prevent the transfer of pathogens through mucosal membranes into the body (Thorgeirsdottir et al. 2003; Thormar et al. 2013).
Fig. 8.

Effect of pH solution on phi6 inactivation for 5-min exposure time with NMC. Asterisk (*) indicates the limit of quantification. Error bars are the standard deviation of triplicate plaque counts for each experiment condition. The control experiment indicates that pH 4 buffer + nano pure water achieved 0.21 (± 0.02) log inactivation of phi6
MS2 (a surrogate for non-enveloped viruses) was treated with NMC and MMC, but MS2 was not inactivated by either (Fig. 9). This result is consistent with those published in the literature about monocaprin being ineffective against non-enveloped viruses (Isaacs et al. 1986; Thormar et al. 1987; Thorgeirsdottir et al. 2003). As mentioned earlier, the antiviral activity of monocaprin is based on the disintegration of the lipid envelope absent in non-enveloped viruses (Sands, 1977, Thormar et al. 1987, 2013; Thormar and Bergsson 2001).
Fig. 9.
Plaque assay results of the antiviral experiment against MS2. A MS2 + TSB (control); B MS2 + 2.5 mM MMC; C MS2 + 2.5 mM NMC. Treatment conditions are 5-min contact time and pH 7. Images show a comparable number of plaques at 10−4 dilution
Cytotoxicity of NMC
Human epithelial (HPDE) and cervical cancer (HeLa) cell lines were used for the cell viability assay to represent the effect of NMC—on normal and cancer cell lines, respectively. Figure 10 shows that NMC was cytocidal at concentration of 2 mM. The obtained IC50 values were 0.22 mM and 0.2 mM for HeLa and HPDE, respectively. Several studies have reported cell death when emulsions of antimicrobial lipids are directly exposed to monolayers of mammalian cells using standard cell viability assays like MTS (Bergsson et al. 1998; Thormar et al. 1999, 2013; Jackman et al. 2016). Nevertheless, this NMC formulation is suggested for usage against the transmission of pathogens through the skin or mucus layer into the body. We expect that they should be suited for these applications because the sensitive mucosal membranes are protected from the environment by the mucus layer (Isaacs et al. 1986; Thormar et al. 2013). Besides, the stomach of suckling infants has a high concentration of antimicrobial lipids after feeding, which does not harm the gastric mucosa (Isaacs et al. 1986; Thormar et al. 2013). This scenario indicates that the mucus layer protects mucosal membranes.
Fig. 10.

Cytotoxicity of NMC on HeLa and HPDE cells
Conclusions
Antiviral lipids are promising antiviral agents. One of the challenges facing the therapeutic applications and performance of antiviral lipids is their poor solubility in aqueous media. Many nanotechnology formulation studies investigating antiviral lipids have aimed to improve their performance by encapsulating them in carriers (Kristmundsdóttir et al. 1999; Jackman et al. 2016; Fletcher et al. 2020). Highly effective antiviral lipids at non-toxic low concentrations in the free form are sometimes desirable. This study demonstrated that simple sonochemistry techniques to generate nanoparticles can improve the solubility and the antiviral activity of monocaprin in the free form. The particle size of NMC decreased, and the antiviral activity increased as sonication time increased from 7 to 20 min. We speculate that the sonication process did not substantially alter the chemical structure of monocaprin based on the absorbance spectra of NMC and MMC. Moreover, the specific antiviral activity of monocaprin was unchanged during the sonication process since NMC inactivated phi6, which has a lipid envelope, but MS2 was not inactivated. The synthesized NMC exhibited higher antiviral activity against phi6 than MMC at pH 7. The MIC of NMC was lower at pH 4 compared to pH 7. The effectiveness of NMC at acidic pH opens the possibility for its use in many pharmaceutical formulations. The lower MIC of NMC than bulk MMC makes it attractive in therapeutic applications where the free form monocaprin emulsions are preferable to encapsulated forms. Many viruses enter the human body by penetrating the mucosal barrier. SARS-CoV-2 can enter the mucosal linings of the mouth, nose, lungs, and eyes (Liu et al. 2016). NMC can be delivered via multiple routes, such as topical, nasal, ophthalmic, or aerosolized, and, as a potentially effective antiviral agent, may reduce infection and transmission of enveloped viruses (e.g., SARS-CoV-2). Future studies should test the effectiveness of NMC against pathogenic enveloped viruses such as SARS-CoV-2.
Author information
AJS and MMM contributed equally to this work and share first authorship. EPV and MM planned and supervised this study. All authors contributed to the study conception and design either in material preparation, data collection, or analysis. AJS and MMM drafted the manuscript and all other authors contributed, read, and approved the final manuscript.
Author contributions
AJS and MMM contributed equally to this work and shared the first authorship. EVP and MM planned and supervised this study. All other authors contributed to the study conception and design either in material preparation, data collection, or analysis. AJS and MMM drafted the manuscript and all other authors contributed, reviewed, and approved the final manuscript.
Funding
EPV was funded by the University of South Carolina ASPIRE I. This study was also funded by the University of North Carolina Charlotte faculty start-up funds.
Data availability
Please contact the author for data requests.
Declarations
Competing interests
The authors declare no competing interests.
Ethics approval and consent to participate
Not applicable.
Consent for publication
Not applicable.
Footnotes
Publisher's note
Springer Nature remains neutral with regard to jurisdictional claims in published maps and institutional affiliations.
Adeola Julian Sorinolu and M. Mustafa Mamun contributed equally to this work.
References
- Aquino De Carvalho N, Stachler EN, Cimabue N, Bibby K. Evaluation of Phi6 persistence and suitability as an enveloped virus surrogate. Environ Sci Technol. 2017;51:8692–8700. doi: 10.1021/acs.est.7b01296. [DOI] [PubMed] [Google Scholar]
- Basheva ES, Kralchevsky PA, Danov KD, Ananthapadmanabhan KP, Lips A. The colloid structural forces as a tool for particle characterization and control of dispersion stability. Phys Chem Chem Phys. 2007;9:5183–5198. doi: 10.1039/b705758j. [DOI] [PubMed] [Google Scholar]
- Bergsson G, Arnfinnsson J, Karlsson SM, Steingrímsson Ó, Thormar H. In vitro inactivation of Chlamydia trachomatis by fatty acids and monoglycerides. Antimicrob Agents Chemother. 1998;42:2290–2294. doi: 10.1128/AAC.42.9.2290. [DOI] [PMC free article] [PubMed] [Google Scholar]
- Bergsson G, Arnfinnsson J, Steingrímsson Ó, Thormar H. Killing of Gram-positive cocci by fatty acids and monoglycerides Note. APMIS. 2001;109:670–678. doi: 10.1034/j.1600-0463.2001.d01-131.x. [DOI] [PubMed] [Google Scholar]
- Bergsson G, Steingrímsson Ó, Thormar H. Bactericidal effects of fatty acids and monoglycerides on Helicobacter pylori. Int J Antimicrob Agents. 2002;20:258–262. doi: 10.1016/S0924-8579(02)00205-4. [DOI] [PubMed] [Google Scholar]
- BW Petschow RP Batema LLJAA Ford CHEMOTHERAPY Susceptibility of Helicobacter pylori to bactericidal properties of medium-chain monoglycerides and free fatty acids. Antimicrob Agents Chemother. 1996;40:302–306. doi: 10.1128/AAC.40.2.302. [DOI] [PMC free article] [PubMed] [Google Scholar]
- Churchward CP, Calder A, Snyder LA (2018) Mutations in Neisseria gonorrhoeae grown in sub-lethal concentrations of monocaprin do not confer resistance. PLoS One 13(4):e0195453 [DOI] [PMC free article] [PubMed]
- Churchward CP, Al-Kinani AA, Abdelkader H, Swinden J, Siwoku O, Varnakulasingam T, Alany RG, Snyder LA. Monocaprin eye drop formulation to combat antibiotic resistant gonococcal blindness. J Scientific Reports. 2020;10:1–10. doi: 10.1038/s41598-020-68722-8. [DOI] [PMC free article] [PubMed] [Google Scholar]
- Fedorenko A, Grinberg M, Orevi T, Kashtan N. Survival of the enveloped bacteriophage Phi6 (a surrogate for SARS-CoV-2) in evaporated saliva microdroplets deposited on glass surfaces. Sci Rep. 2020;10:1–10. doi: 10.1038/s41598-020-79625-z. [DOI] [PMC free article] [PubMed] [Google Scholar]
- Fernandes MM, Francesko A, Torrent-Burgués J, Carrión-Fité FJ, Heinze T, Tzanov T. Sonochemically processed cationic nanocapsules: efficient antimicrobials with membrane disturbing capacity. Biomacromol. 2014;15:1365–1374. doi: 10.1021/bm4018947. [DOI] [PubMed] [Google Scholar]
- Fernandes MM, Ivanova K, Francesko A, Rivera D, Torrent-Burgués J, Gedanken A, Mendonza E, Tzanov T. Escherichia coli and Pseudomonas aeruginosa eradication by nano-penicillin G. Nanomedicine: Nanotechnology. Biol Med. 2016;12:2061–2069. doi: 10.1016/j.nano.2016.05.018. [DOI] [PubMed] [Google Scholar]
- Fletcher NF, Meredith LW, Tidswell EL, Bryden SR, Gonçalves-Carneiro D, Chaudhry Y, Shannon-Lowe C, Folan MA, Lefteri DA, Pingen M, Bailey D, McKimmie CS, Baird AW. A novel antiviral formulation inhibits a range of enveloped viruses. J Gen Virol. 2020;101:1090–1102. doi: 10.1099/jgv.0.001472. [DOI] [PubMed] [Google Scholar]
- Gedanken A (2003) Sonochemistry and its application to nanochemistry. Curr Sci 1720–1722
- Gedanken A. Using sonochemistry for the fabrication of nanomaterials. Ultrason Sonochem. 2004;11:47–55. doi: 10.1016/j.ultsonch.2004.01.037. [DOI] [PubMed] [Google Scholar]
- Gude VG, Grant GE. Biodiesel from waste cooking oils via direct sonication. Appl Energy. 2013;109:135–144. doi: 10.1016/j.apenergy.2013.04.002. [DOI] [Google Scholar]
- Gupta N, Rai DB, Jangid AK, Kulhari H (2019) Use of nanotechnology in antimicrobial therapy. Methods in Microbiology Elsevier 46:143–172
- H Thormar CE Isaacs HR Brown MR Barshatzky TJAA Pessolano CHEMOTHERAPY Inactivation of enveloped viruses and killing of cells by fatty acids and monoglycerides. J Antimicrob Agents Chemother. 1987;31:27–31. doi: 10.1128/AAC.31.1.27. [DOI] [PMC free article] [PubMed] [Google Scholar]
- Isaacs CE, Thormar H, Pessolano T. Membrane-disruptive effect of human milk: inactivation of enveloped viruses. J Infect Dis. 1986;154:966–971. doi: 10.1093/infdis/154.6.966. [DOI] [PMC free article] [PubMed] [Google Scholar]
- Jackman JA, Yoon BK, Li D, Cho NJ. Nanotechnology formulations for antibacterial free fatty acids and monoglycerides. Molecules. 2016;21:305. doi: 10.3390/molecules21030305. [DOI] [PMC free article] [PubMed] [Google Scholar]
- JJ Kabara DM Swieczkowski AJ Conley JPJAA Truant Chemotherapy Fatty acids and derivatives as antimicrobial agents. Antimicrob Agents Chemother. 1972;2:23–28. doi: 10.1128/AAC.2.1.23. [DOI] [PMC free article] [PubMed] [Google Scholar]
- Kabara JJ. Structure-function relationships of surfactants as antimicrobial agents. Soc Cosmet Chemists. 1978;29:733–741. [Google Scholar]
- Kabara J, Vrable R, Lie KJM. Antimicrobial lipids: natural and synthetic fatty acids and monoglycerides. Lipids. 1977;12:753–759. doi: 10.1007/BF02570908. [DOI] [PubMed] [Google Scholar]
- Kohn A, Gitelman J, Inbar M. Unsaturated free fatty acids inactivate animal enveloped viruses. Adv Virol. 1980;66:301–307. doi: 10.1007/BF01320626. [DOI] [PubMed] [Google Scholar]
- Kristmundsdóttir T, Árnadóttir SG, Bergsson G, Thormar H. Development and evaluation of microbicidal hydrogels containing monoglyceride as the active ingredient. J Pharm Sci. 1999;88:1011–1015. doi: 10.1021/js9900396. [DOI] [PubMed] [Google Scholar]
- Liu L, Wei Q, Nishiura K, Peng J, Wang H, Midkiff C, Alvarez X, Qin C, Lackner A, Chen Z. Spatiotemporal interplay of severe acute respiratory syndrome coronavirus and respiratory mucosal cells drives viral dissemination in rhesus macaques. Mucosal Immunol. 2016;9:1089–1101. doi: 10.1038/mi.2015.127. [DOI] [PMC free article] [PubMed] [Google Scholar]
- Mamun MM, Sorinlou AJ, Munir M, Vejerano EP (2021) Nanoantibiotics: functions and properties at the nanoscale to combat antibiotic resistance. Front Chem 9:687660 [DOI] [PMC free article] [PubMed]
- Qiao Y, Yang M, Marabella IA, Mcgee DA, Aboubakr H, Goyal S, Hogan CJ, Jr, Olson BA, Torremorell M. Greater than 3-log reduction in viable coronavirus aerosol concentration in ducted ultraviolet-C (UV–C) systems. Environ Sci Technol. 2020;55:4174–4182. doi: 10.1021/acs.est.0c05763. [DOI] [PubMed] [Google Scholar]
- Qiao SZ, Liu J, Lu GQM (2011) Synthetic chemistry of nanomaterials. Modern Inorganic Synt Chem 479–506
- Samimi S, Maghsoudnia N, Eftekhari RB, Dorkoosh F 2019 Lipid-based nanoparticles for drug delivery systems. Charact Biol Nanomater Drug Deliv 47–76
- Sands JA. Inactivation and inhibition of replication of the enveloped bacteriophage φ6 by fatty acids. Antimicrob Agents Chemother. 1977;12:523–528. doi: 10.1128/AAC.12.4.523. [DOI] [PMC free article] [PubMed] [Google Scholar]
- São Pedro A, Santo I, Silva C, Detoni C, Albuquerque E (2013) The use of nanotechnology as an approach for essential oil-based formulations with antimicrobial activity. Formatex Research Center Pulisher 2:1364–1374
- Sinclair RG, Rose JB, Hashsham SA, Gerba CP, Haas CN. Criteria for selection of surrogates used to study the fate and control of pathogens in the environment. Appl Environ Microbiol. 2012;78:1969–1977. doi: 10.1128/AEM.06582-11. [DOI] [PMC free article] [PubMed] [Google Scholar]
- Singh R, Smitha MS, Singh SP. The role of nanotechnology in combating multi-drug resistant bacteria. J Nanosci Nanotechnol. 2014;14:4745–4756. doi: 10.1166/jnn.2014.9527. [DOI] [PubMed] [Google Scholar]
- Suslick KS, Crum LA. Sonochemistry and Sonoluminescence. Encycl Acoust. 1997;1:271–281. [Google Scholar]
- Tan P, Fu H, Ma X (2021) Design, optimization, and nanotechnology of antimicrobial peptides: from exploration to applications. Nano Today 39:101229. 10.1016/j.nantod.2021.101229
- Thorgeirsdottir T, Thormar H, Kristmundsdottir T. Effects of polysorbates on antiviral and antibacterial activity of monoglyceride in pharmaceutical formulations. An Int J Pharm Sci. 2003;58:286–287. [PubMed] [Google Scholar]
- Thormar H, Bergsson G, Gunnarsson E, Georgsson G, Witvrouw M, Steingrimsson O, de Clercq E, Kristmundsdóttir T (1999) Hydrogels containing monocaprin have potent microbicidal activities against sexually transmitted viruses and bacteria in vitro. Sex Transm Infect 75(3):181–151 [DOI] [PMC free article] [PubMed]
- Thormar H, Hilmarsson H, Bergsson G. Stable concentrated emulsions of the 1-monoglyceride of capric acid (monocaprin) with microbicidal activities against the food-borne bacteria Campylobacter jejuni, Salmonella spp., and Escherichia coli. Appl Environ Microbiol. 2006;72:522–526. doi: 10.1128/AEM.72.1.522-526.2006. [DOI] [PMC free article] [PubMed] [Google Scholar]
- Thormar H, Hilmarsson H, Bergsson G. Antimicrobial lipids: Role in innate immunity and potential use in prevention and treatment of infections. J Microbial Pathogens & Strategies for Combating Them: Science, Technology & Education. 2013;3:1474–1488. [Google Scholar]
- Thormar H (2011) Antibacterial effects of lipids: historical review (1881 to 1960). J Lipids Essential Oils 25
- Thormar H, Bergsson G (2001) Antimicrobial effects of lipids. Recent Dev Antivir Res 157–173
- Tseng C-C, Li C-S. Inactivation of viruses on surfaces by ultraviolet germicidal irradiation. J Occup Environ Hyg. 2007;4:400–405. doi: 10.1080/15459620701329012. [DOI] [PMC free article] [PubMed] [Google Scholar]
- Vatter P, Hoenes K, Hessling M. Photoinactivation of the coronavirus surrogate phi6 by visible light. Photochem Photobiol. 2021;97:122–125. doi: 10.1111/php.13352. [DOI] [PubMed] [Google Scholar]
- Wanda P, Cupp J, Snipes W, Keith A, Rucinsky T, Polish L, Sands J. Inactivation of the enveloped bacteriophage ø6 by butylated hydroxytoluene and butylated hydroxyanisole. Antimicrob Agents Chemother. 1976;10:96–101. doi: 10.1128/AAC.10.1.96. [DOI] [PMC free article] [PubMed] [Google Scholar]
- Wang L-L, Johnson EA. Inhibition of Listeria monocytogenes by fatty acids and monoglycerides. Appl Environ Microbiol. 1992;58:624–629. doi: 10.1128/aem.58.2.624-629.1992. [DOI] [PMC free article] [PubMed] [Google Scholar]
- Wigginton KR, Pecson BM, Sigstam T, Bosshard F, Kohn T. Virus inactivation mechanisms: impact of disinfectants on virus function and structural integrity. Environ Sci Technol. 2012;46:12069–12078. doi: 10.1021/es3029473. [DOI] [PubMed] [Google Scholar]
- Wood JP, Richter W, Sunderman M, Calfee MW, Serre S, Mickelsen L. Evaluating the environmental persistence and inactivation of MS2 bacteriophage and the presumed Ebola virus surrogate Phi6 using low concentration hydrogen peroxide vapor. Environ Sci Technol. 2020;54:3581–3590. doi: 10.1021/acs.est.9b06034. [DOI] [PMC free article] [PubMed] [Google Scholar]
- Xu P, Zeng GM, Huang DL, Feng CL, Hu S, Zhao MH, Lai C, Wei Z, Huang C, Xie GX, Liu ZF. Use of iron oxide nanomaterials in wastewater treatment: a review. Sci Total Environ. 2012;424:1–10. doi: 10.1016/j.scitotenv.2012.02.023. [DOI] [PubMed] [Google Scholar]
- Yariv I, Lipovsky A, Gedanken A, Lubart R, Fixler D (2015) Enhanced pharmacological activity of vitamin b12 and penicillin as nanoparticles. Int J Nanomed 10(1):3593–3601 [DOI] [PMC free article] [PubMed]
- Ye Y, Ellenberg RM, Graham KE, Wigginton KR. Survivability, partitioning, and recovery of enveloped viruses in untreated municipal wastewater. Environ Sci Technol. 2016;50:5077–5085. doi: 10.1021/acs.est.6b00876. [DOI] [PubMed] [Google Scholar]
Associated Data
This section collects any data citations, data availability statements, or supplementary materials included in this article.
Data Availability Statement
Please contact the author for data requests.